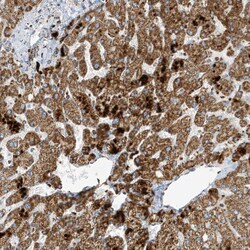

Promotional price valid on web orders only. Your contract pricing may differ. Interested in signing up for a dedicated account number?
Learn More
Learn More
Invitrogen™ ATP5I Polyclonal Antibody


Rabbit Polyclonal Antibody
Supplier: Invitrogen™ PA557112
Description
Immunogen sequence: RRIAAEEKKK QDELKRIARE LAEDDSILK Highest antigen sequence identity to the following orthologs: Mouse - 84%, Rat - 69%.
Mitochondrial ATP synthases (ATPases) transduce the energy contained in membrane electrochemical proton gradients into the energy required for synthesis of high-energy phosphate bonds. ATPases contain two linked complexes: F1, the hydrophilic catalytic core; and F0, the membrane-embedded protein channel. The two complexes are linked by a central stalk and a peripheral stalk. During catalysis, ATP synthesis in the catalytic domain of F1 is coupled, via a rotary mechanism of the central stalk subunits, with proton translocation across the membrane. ATP5I, also known as mitochondrial ATP synthase subunit E or ATP5K, is a 69 amino acid protein member of the ATPase E subunit family. Localized to the inner membrane of the mitochondria, ATP5I is a part of the F0 complex.
Specifications
| ATP5I | |
| Polyclonal | |
| Unconjugated | |
| Atp5me | |
| 2610008D24Rik; ATP synthase e chain, mitochondrial; ATP synthase membrane subunit e; ATP synthase subunit e, mitochondrial; ATP synthase subunit e, mitochondrial, N-terminally processed; ATP synthase, H+ transporting, mitochondrial F0 complex, subunit E; ATP synthase, H+ transporting, mitochondrial F1F0 complex, subunit e; ATP synthase, H+ transporting, mitochondrial Fo complex subunit E; ATP synthase, H+ transporting, mitochondrial Fo complex, subunit E; Atp5i; Atp5k; Atp5me; ATPase subunit e; F1F0-ATP synthase, murine e subunit; Lfm1; Lfm-1 | |
| Rabbit | |
| Antigen affinity chromatography | |
| RUO | |
| 11958, 140608, 521 | |
| Store at 4°C short term. For long term storage, store at -20°C, avoiding freeze/thaw cycles. | |
| Liquid |
| Immunohistochemistry (Paraffin), Western Blot, Immunocytochemistry | |
| 0.4 mg/mL | |
| PBS with 40% glycerol and 0.02% sodium azide; pH 7.2 | |
| P29419, P56385, Q06185 | |
| Atp5me | |
| Recombinant protein corresponding to Human ATP5I. Recombinant protein control fragment (Product #RP-96729). | |
| 100 μL | |
| Primary | |
| Human, Mouse, Rat | |
| Antibody | |
| IgG |
Product Content Correction
Your input is important to us. Please complete this form to provide feedback related to the content on this product.
Product Title
Spot an opportunity for improvement?Share a Content Correction